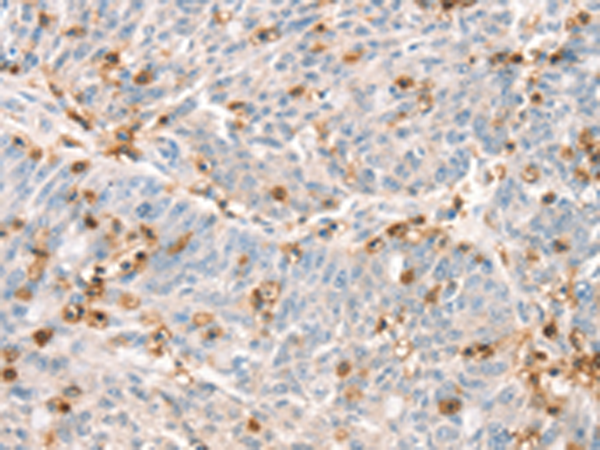
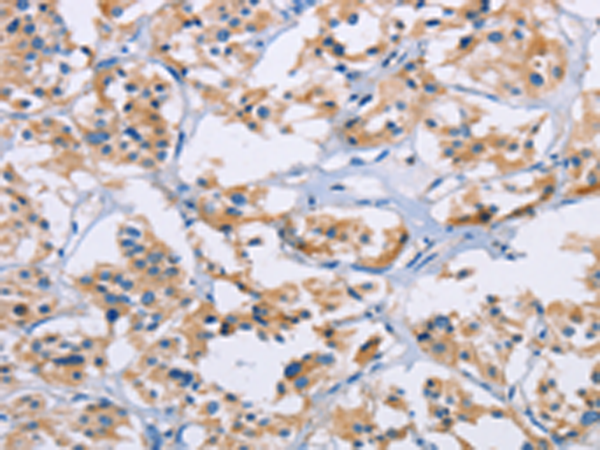

-
分类: 科研抗体货号: P08135别名: LSN; CD43; GALGP; GPL115应用: IHC反应种属: Human
-
分类: 科研抗体货号: P08114别名: END; HHT1; ORW1应用: WB,IHC反应种属: Human
-
分类: 科研抗体货号: P08097别名: IV; caMK; CaMK IV; CaMK-GR应用: WB,IHC反应种属: Human, Mouse, Rat
-
分类: 科研抗体货号: P08113别名: GPR28; CDw199; GPR-9-6; CC-CKR-9应用: IHC反应种属: Human, Mouse
-
分类: 科研抗体货号: P08134别名: IGM; IMD3; TRAP; gp39; CD154; CD40L; HIGM1; T-BAM; TNFSF5; hCD40L应用: WB反应种属: Human, Mouse
-
分类: 科研抗体货号: P08094别名: PDIB2应用: IHC反应种属: Human, Mouse, Rat
-
分类: 科研抗体货号: P08133别名: 1C7; MALS; CD337; LY117; NKp30应用: IHC反应种属: Human
-
分类: 科研抗体货号: P08112别名: ZNF581; HSU79303应用: IHC反应种属: Human, Mouse
-
分类: 科研抗体货号: P08093别名: BS-17应用: WB,IHC反应种属: Human
-
分类: 科研抗体货号: P08092别名: CALN; CCN1; CNA1; CALNA; PPP2B; CALNA1应用: WB,IHC反应种属: Human, Mouse, Rat

鄂公网安备42018502007531号
鄂公网安备42018502007531号

